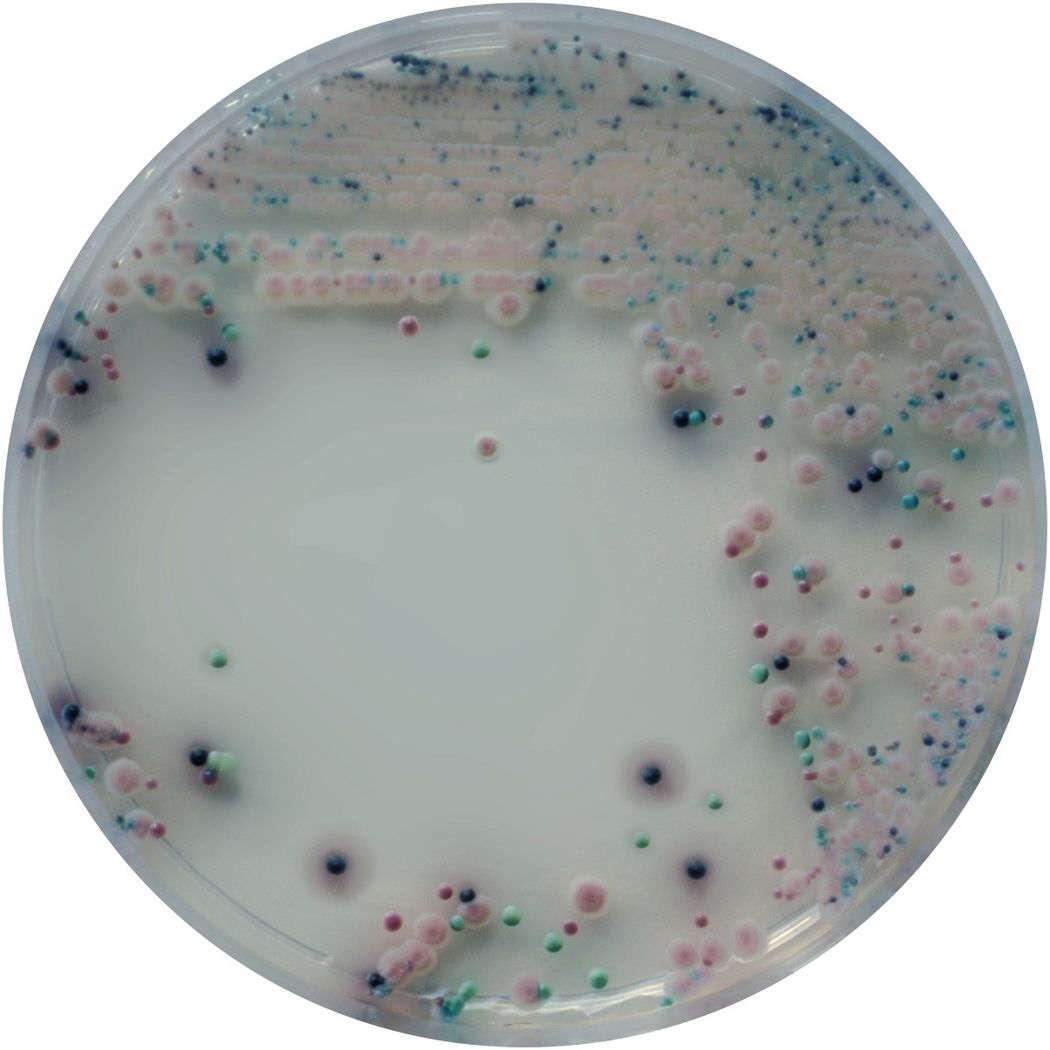
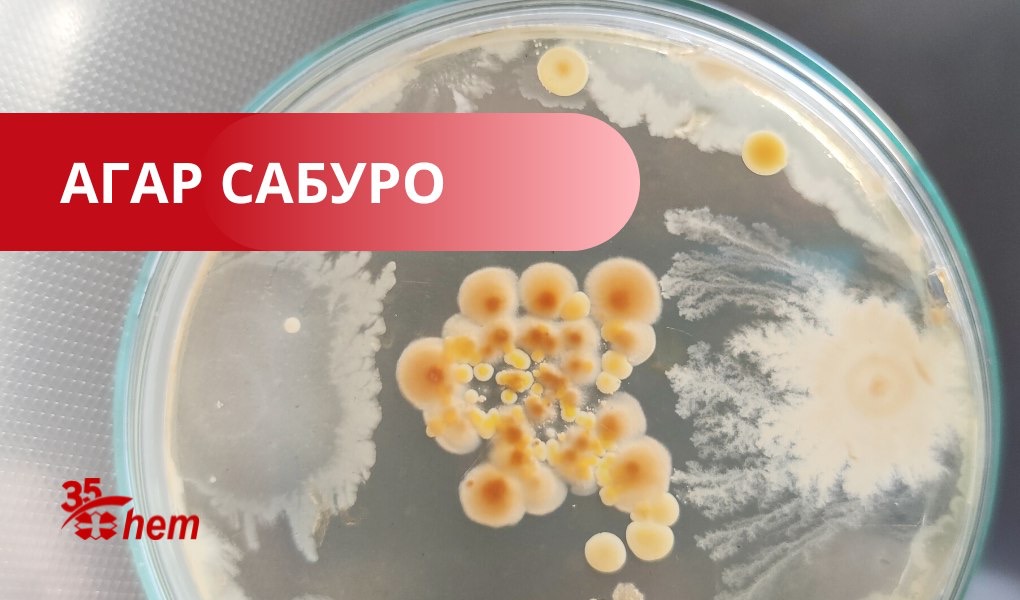
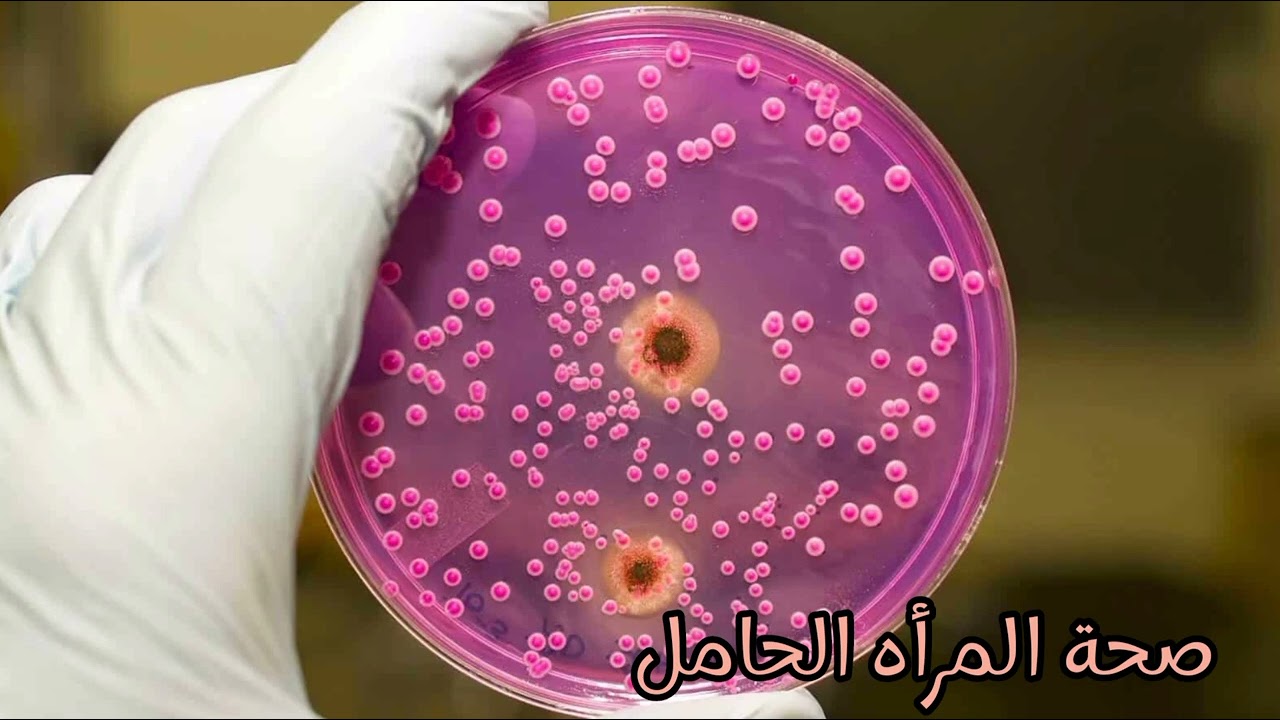
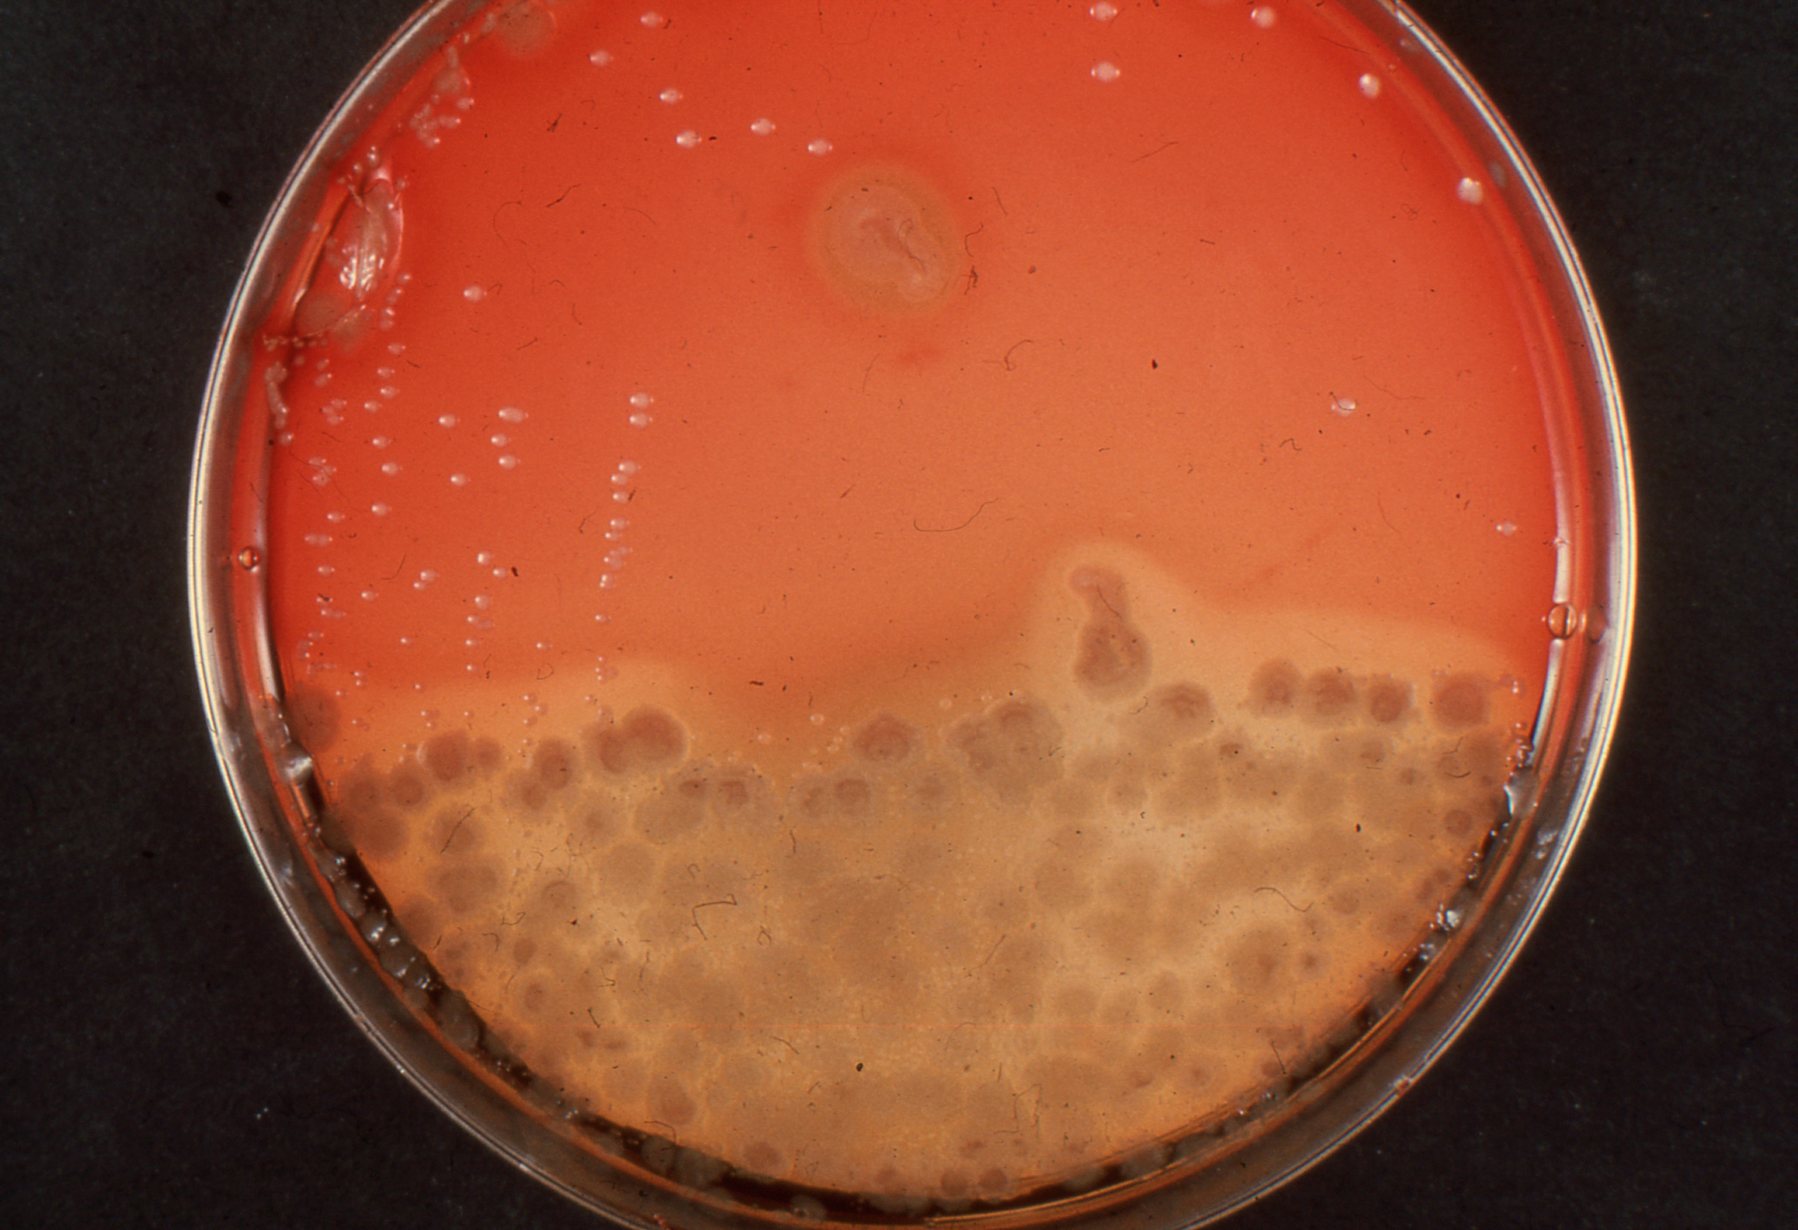

Кандида агар
Кандида агар 142 фото
Нашел карту псб
Малыш теленок
Лучший препарат от газов
Всд скоростной диаметр
Математика 6 класс виленкин номер п 89
Набор инструментов kraftool 27978 h131
Закрытые интернет тарифы
Типы хомутов для труб
Расширительный бак приору
Роль традиции в развитии общества
Риски ремонта оборудования
Какие лекарства пить чтобы забеременеть
Деловые линии отследить по трек номеру заказ
Крем для пяток и натоптышей
Royal bath alpine
После дождя книга
Покажи кейс standoff 2
Самостоятельная работа по географии по теме поволжье
Cover license
Яценко воронеж